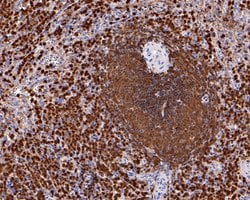
Invitrogen p47phox Monoclonal Antibody (A6B11) 100 &mu;L; Unconjugated:Antibodies,

missing translation for 'onlineSavingsMsg'
Learn More
Learn More
Invitrogen™ p47phox Monoclonal Antibody (A6B11)


Mouse Monoclonal Antibody
Brand: Invitrogen™ MA542546
Dieser Artikel kann nicht zurückgegeben werden.
Rückgaberichtlinie anzeigen
Beschreibung
Positive Control: Raji cell lysates, Daudi cell lysates, Hela, NIH/3T3, human lung tissue, human spleen tissue, Daudi. Subcellular Location: Cytosol, Membrane.
p47phox (NCF1) is required, along with NCF2 and membrane bound cytochrome b558, for activation of the latent NADPH oxidase. This oxidase is a multicomponent enzyme that is activated to produce superoxide anion. Mutations in the gene can result in granulomatous disease.
Spezifikation
| p47phox | |
| Monoclonal | |
| 2 mg/mL | |
| PBS with 0.05% BSA, 40% glycerol and 0.05% sodium azide; pH 7.4 | |
| P14598, Q09014 | |
| Ncf1 | |
| Recombinant protein within human p47-phox aa 51-250. | |
| 100 μL | |
| Primary | |
| Human, Mouse | |
| Antibody | |
| IgG1 |
| Immunohistochemistry (Paraffin), Western Blot, Immunocytochemistry | |
| A6B11 | |
| Unconjugated | |
| Ncf1 | |
| 47 kDa autosomal chronic granulomatous disease protein; 47 kDa neutrophil oxidase factor; NADPH oxidase organizer 2; NADPH oxidase subunit (47 kD); NADPH oxidase subunit (47kDa); Ncf1; NCF-1; NCF1A; NCF-47K; neutrop; neutrophil cytosol factor 1; neutrophil cytosolic factor 1; neutrophil cytosolic factor 1, (chronic granulomatous disease, autosomal 1); neutrophil NADPH oxidase factor 1; Nox organizer 2; NOXO2; nox-organizing protein 2; P47 phox; p47>phox>; p47phox; p47-phox; phagocyte oxidase 47 kDa; SH3 and PX domain-containing protein 1A; SH3PXD1A | |
| Mouse | |
| Protein G | |
| RUO | |
| 17969, 653361 | |
| Store at 4°C short term. For long term storage, store at -20°C, avoiding freeze/thaw cycles. | |
| Liquid |
Berichtigung von Produktinhalten
Bitte geben Sie uns Ihr Feedback zu den Produktinhalten, indem Sie das folgende Formular ausfüllen.
Name des Produkts
Haben Sie Verbesserungsvorschläge?Übermitteln Sie eine inhaltliche Korrektur